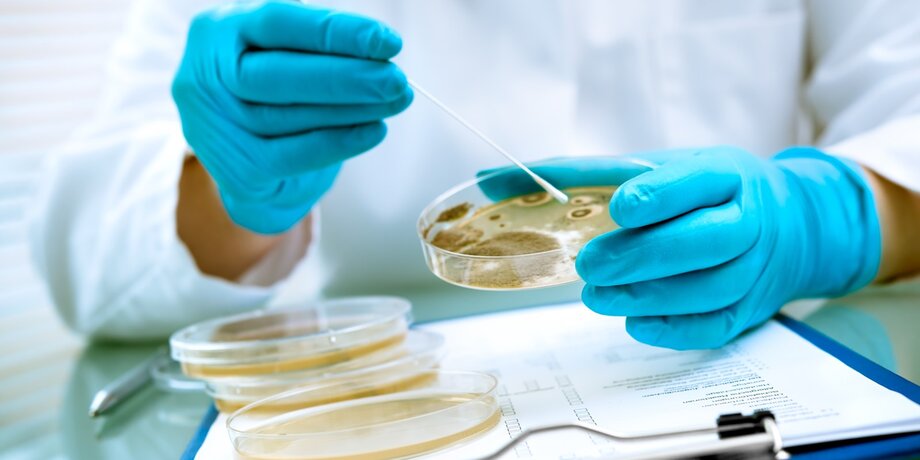

Опасную бактерию Vibrio обнаружили у берегов Турции. Специалисты предупреждают о необходимости соблюдать меры предосторожности при контакте с морской водой, а также внимательно следить за своим рационом на отдыхе. Подробнее – в материале Москва 24.
Отдых опасен?
Бактерию Vibrio, вызывающую холеру, обнаружили у берегов Мраморного, Эгейского и Средиземного морей. Турецкие врачи предупредили, что некоторые из ее разновидностей могут спровоцировать заболевание, характеризующееся диареей и потерей жидкости, что приводит к тканевым инфекциям, сепсису и некротизирующему фасцииту (инфекционное заболевание, отличающееся быстрым распространением и разрушением мягких тканей).
Однако Минздрав Турции не получал данных о заболеваниях, вызванных бактериями Vibrio, сообщили ТАСС в пресс-службе министерства. Не было массовых жалоб от путешественников и в сторону туроператоров, рассказал "Звезде" руководитель пресс-службы Российского союза туриндустрии Артур Абдюханов. По его словам, обращений не поступало и в страховые компании.
В Ассоциации туроператоров России (АТОР), в свою очередь, отметили, что у отдыхающих нет поводов для паники. В тексте на сайте объединения назвали пересказ материалов турецких СМИ в соцсетях "набором неграмотной и антинаучной информации вместе с плохим переводом".
По данным АТОР, за весь 2024 год было зафиксировано менее 20 подтвержденных инцидентов на всем побережье Турции. Также эксперты подчеркнули, что местные власти еженедельно тестируют воду, и, если норма концентрации бактерий превышается, пляж закрывают. Там, где купание разрешено, это не несет никаких угроз, подчеркнули в ассоциации.
Как не заразиться?
Роспотребнадзор находится в контакте с Минздравом Турции из-за ситуации с бактериями Vibrio, рассказали в пресс-службе ведомства. Также специалисты продолжают мониторить обстановку, чтобы инфекция не попала на территорию России, подчеркнули там.
В целом же распространение бактерий Vibrio имеет сезонный характер, подчеркнули в Роспотребнадзоре. Заболеваемость обычно возникает после употребления морепродуктов, а также при контакте с водой или через поврежденные кожные покровы.
"Несмотря на то что случаи заражения вибрионами остаются относительно редкими, Роспотребнадзор напоминает о необходимости соблюдения мер профилактики для обеспечения безопасности во время отдыха за рубежом", – отметили в ведомстве.
Кроме того, в Роспотребнадзоре посоветовали не забывать о мытье рук, пить только кипяченую или бутилированную воду и избегать людей с признаками инфекции. Также не стоит использовать лед, замороженный из некипяченой воды.
Больше других заражению подвержены дети младше 5 и пожилые старше 60 лет, рассказала Москве 24 врач-инфекционист Елена Мескина.
"Также в зоне риска страдающие хроническими заболеваниями, в особенности желудочно-кишечного тракта. Они более восприимчивы к бактериям, и им достаточно малой концентрации, чтобы заразиться", – сказала специалист.
При подозрениях, что на территории отеля есть зараженные, врач порекомендовала воздержаться от купания.
"Это классические водные инфекции, поэтому надо внимательно относиться к отдыху не только в море, но и в бассейне. Люди могут быть переносчиками, и другой водоем, даже если он искусственный, может быть заражен. Но если в отеле соблюдаются правила обработки, то это безопасно", – подчеркнула Мескина.
Кроме экзотической еды вроде мидий и моллюсков, она посоветовала не забывать о рекомендациях мыть овощи, фрукты и ягоды перед употреблением в пищу.
Сергей Собянин: метродепо "Руднево" исполнилось шесть лет